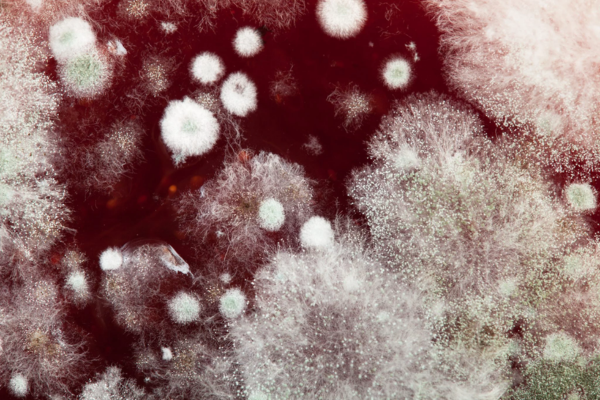

NUEVA ¡Nueva oportunidad de inversión!
Comprea ¡NUEVA OPORTUNIDAD!
Lorem ipsum dolor sit amet, consectetur adipisicing elit. Architecto eligendi dicta, error veritatis, eligendi dicta, error veritatis, Lorem ipsum dolor sit amet...

INVERSOR REFERENCIA
Perico Palotes
INVIERTE
50.0000€
Invertido
300.000€
Objetivo
275.000€
- 450 Interesados
- 136 Inversores
- 150.2% Completado